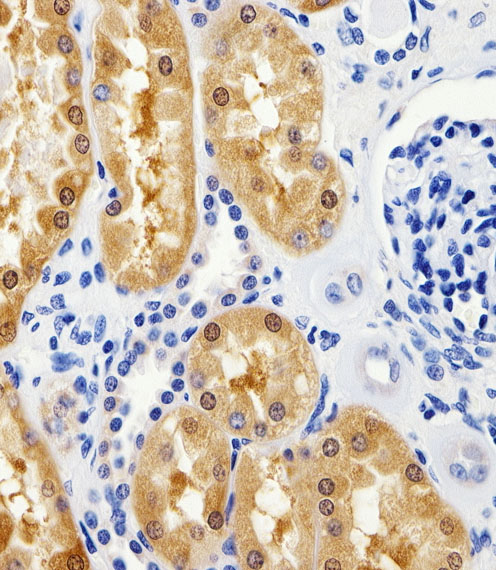

> Antigen, Antibodies, ELISA, Western Blot > Primary Antibody > Polyclonal Antibodies > GPT Antibody (N-term R133)Brand |
Leading Biology | Catalog Number |
AMM05206G |
Product Type |
Polyclonal Antibodies | Field of Research |
|
Product Overview |
We constantly strive to ensure we provide our customers with the best antibodies. As a result of this work we offer this antibody in purified format.
We are in the process of updating our datasheets. If you have any questions regarding this update, please feel free to contact our technical support team.
This product is a high quality GPT antibody (N-term R133).
|
||
Molecular Weight |
54637 Da
|
||
Cellular Localization |
Antigen Cellular Localization:
Cytoplasm.
|
||
Host |
Rabbit
|
||
Species Reactivity |
Human, Mouse, Rat
|
||
Immunogen |
118-144 aa
|
||
Target |
This GPT antibody is generated from rabbits immunized with a KLH conjugated synthetic peptide between 118-144 amino acids from the N-terminal region of human GPT.
|
||
Isotype |
Rabbit Ig
|
||
Symbol |
AAT1, GPT1
|
||
GeneID |
|||
UniProt ID |
|||
Function |
Catalyzes the reversible transamination between alanine and 2-oxoglutarate to form pyruvate and glutamate. Participates in cellular nitrogen metabolism and also in liver gluconeogenesis starting with precursors transported from skeletal muscles (By similarity).
|
||
Summary |
GPT(Glutamate-pyruvate transaminase), also known as alanine aminotransferase, catalyzes the reversible conversion of L-alanine and alpha-ketoglutarate to L-glutamate and pyruvate. This protein has 2 distinct molecular and genetic forms: one cytoplasmic (soluble) (GPT1) and one mitochondrial (GPT2). See ALTQTL1 and ALTQTL2 for information on quantitative trait loci influencing the plasma level of alanine aminotransferase.
|
||
Form |
Purified polyclonal antibody supplied in PBS with 0.09% (W/V) sodium azide. This antibody is prepared by Saturated Ammonium Sulfate (SAS) precipitation followed by dialysis against PBS. |
||
Storage & Stability |
Store at +4°C short term. For long-term storage, aliquot and store at -20°C or below. Stable for 12 months at -20°C. Avoid repeated freeze-thaw cycles.
|
||
Applications |
WB, IHC-P, E
|
||
Dilution |
IHC-P~~1:100
WB~~1:1000
|
||
Synonyms |
Alanine aminotransferase 1, ALT1, Glutamate pyruvate transaminase 1, GPT 1, Glutamic--alanine transaminase 1, Glutamic--pyruvic transaminase 1, GPT, AAT1, GPT1
|
||
Images |

Immunohistochemical analysis of paraffin-embedded H.liver section using GPT Antibody (N-term R133)( AMM05206G). AMM05206G was diluted at 1:100 dilution. A peroxidase-conjugated goat anti-rabbit IgG at 1:400 dilution was used as the secondary antibody, followed by DAB staining.
Immunohistochemical analysis of paraffin-embedded H.kidney section using GPT Antibody (N-term R133)( AMM05206G). AMM05206G was diluted at 1:100 dilution. A peroxidase-conjugated goat anti-rabbit IgG at 1:400 dilution was used as the secondary antibody, followed by DAB staining. 
GPT Antibody (N-term R133) (Cat. AMM05206G) western blot analysis in U87-MG cell line , mouse liver ,and rat heart and liver tissue lysates (35ug/lane).This demonstrates the GPT antibody detected the GPT protein (arrow). |
||
Specification |
|||
Quantity |
|
||
| Select | Brand | Catalog No. | Product Name | Pack Size | Type | Field of Research | Specification | Quantity | Price(USD) | |
| 1 | Leading Biology | APR03440G | ITGA11 Antibody (N-term) | 100 μl | Polyclonal Antibodies |
|
$495.00 | Add Ask | ||
| 2 | Leading Biology | APR04537G | CMIP Antibody (C-term) | 100 μl | Polyclonal Antibodies |
|
$495.00 | Add Ask | ||
| 3 | Leading Biology | APR12422G | Human H4 Histamine Receptor (extracellular) Antibody | 50 μl | Polyclonal Antibodies |
|
$695.00 | Add Ask | ||
| 4 | Leading Biology | APR03844G | UBE2W Antibody (C-term) | 100 μl | Polyclonal Antibodies |
|
$495.00 | Add Ask | ||
| 5 | Leading Biology | APR04349G | HECTD2 Antibody (N-term) | 100 μl | Polyclonal Antibodies |
|
$495.00 | Add Ask | ||
| 6 | Leading Biology | APR03502G | IGHG1 Antibody (Center) | 100 μl | Polyclonal Antibodies |
|
$495.00 | Add Ask |
 Leading Biology Inc.
2600 Hilltop DR, Building G, B Suite C138
Richmond, CA, 94806
Tel: 1-661-524(LBI)-0262
Email: info@leadingbiology.com
Leading Biology Inc.
2600 Hilltop DR, Building G, B Suite C138
Richmond, CA, 94806
Tel: 1-661-524(LBI)-0262
Email: info@leadingbiology.com
Complete this form and click send to ask us a question, request a quote or simply say hello.

You have 0 item in your cart

You have 0 item in your inquiry list
